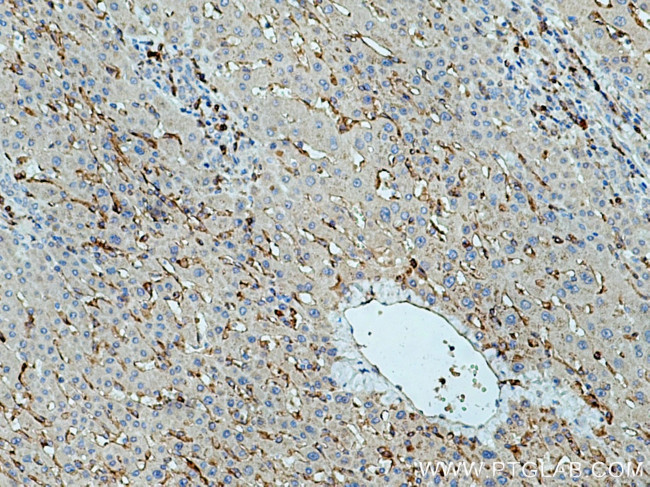
SIGLEC9 Antibody in Immunohistochemistry (Paraffin) (IHC (P))

Search
Proteintech
SIGLEC9 Polyclonal Antibody
{{$productOrderCtrl.translations['antibody.pdp.commerceCard.promotion.promotions']}}
{{$productOrderCtrl.translations['antibody.pdp.commerceCard.promotion.viewpromo']}}
{{$productOrderCtrl.translations['antibody.pdp.commerceCard.promotion.promocode']}}: {{promo.promoCode}} {{promo.promoTitle}} {{promo.promoDescription}}. {{$productOrderCtrl.translations['antibody.pdp.commerceCard.promotion.learnmore']}}
产品信息
13377-1-AP
种属反应
宿主/亚型
分类
类型
抗原
偶联物
形式
浓度
规格
纯化类型
保存液
内含物
保存条件
运输条件
产品详细信息
Immunogen sequence: LTCQVTFPG ASVTTNKTVH LNVSYPPQNL TMTVFQGDGT VSTVLGNGSS LSLPEGQSLR LVCAVDAVDS NPPARLSLSW RGLTLCPSQP SNPGVLELPW VHLRDEAEFT CRAQNPLGSQ QVYLNVSLQS KA (211-341 aa encoded by BC035365)
靶标信息
SIGLEC9 (Sialic acid-binding Ig-like lectin 9) is a putative adhesion molecule that mediates sialic-acid dependent binding to cells. It contains two Ig-like C2 type (immunoglobulin-like) domains and one Ig-like V-type (immunoglobulin-like) domain. It preferentially binds to alpha2, 3-or alpha2, 6-linked sialic acid. The sialic acid recognition site may be mased by cis interactions with sialic acids on the same cell surface.
仅用于科研。不用于诊断过程。未经明确授权不得转售。
篇参考文献 (0)
生物信息学
蛋白别名: CD329; CDw329; Protein FOAP-9; Sialic acid-binding Ig-like lectin 9; Siglec; Siglec-9; unnamed protein product
基因别名: CD329; CDw329; FOAP-9; OBBP-LIKE; siglec-9; SIGLEC9; UNQ668/PRO1302
UniProt ID: (Human) Q9Y336
Entrez Gene ID: (Human) 27180